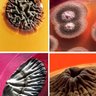
microBIOblog's profile picture. Divulgación científica, noticias y curiosidades sobre virus, bacterias y otros temas relacionados con la ciencia. No discuto en Twitter.  (Ignacio López-Goñi).

Alejandro Navarro Yáñez
@Alexny_85
Bioquímico y economista 🔬💰🏺Influencer en prácticas. Trabajo para los Illuminati. La 🌍 no es plana. @cescept @hdciencia 📚en @almuzaralibros
You might like
¿Tan oscura fue la Edad Media? ¡Hace muchos siglos, en Suecia, un desconocido monje-cirujano del monasterio de Varnham remachó este asombroso implante de cobre en un miembro malherido, consiguiendo que se regenerase nuevo tejido óseo! 📷: Historiska Museet Stockholm

Una desastrosa decisión cuyas consecuencias pagaremos todos. 😡 elpais.com/us/2026-02-12/…
Este candado de oro encontrado en Alemania y recién restaurado resultaría menos impresionante…¡si no fuera porque es de época imperial romana! Francamente, atestigua un nivel de tecnología increíble para el s III… 📷 Asociación Regional Westfalia-Lippe


Construido hace mil años, el templo Kandariya Mahadeva, en la India, es una de las construcciones más asombrosas del planeta. ¡A sus famosos relieves eróticos, añade en la parte superior una extraordinaria decoración que se asemeja a un fractal! 📷 Kevinstandagehotography

En Dinamarca, hace 3400 años, una mujer fue enterrada en un tronco de roble. Lo sorprendente es que la cuenta de vidrio azul encontrada a su lado…¡procedía del taller egipcio que suministró el vaso de cristal hallado en la tumba de Tutankamón, a más de 5000 km! 📷Science Nordic


¡Un auténtico placer dar esta conferencia en la Olimpiada de Química! Si estáis el próximo 7 de marzo por Alcalá, allí os espero…

Cuando vemos en los museos las formidables piezas del pasado, no nos damos cuenta del magnífico trabajo que hacen los restauradores... ¡Esta espectacular daga romana de plata, con 2000 años de antigüedad, fue encontrada en Alemania y restaurada durante 9 meses! 📷DPA/PA Images

¿Cómo protegían los romanos sus viviendas ? Pues con llaves, como nosotros. Bueno, como nosotros no, ¡las suyas eran más chulas y estilosas! Aquí,👇algunos ejemplos…

Durísimo y con los puntos de fusión y ebullición más altos de entre todos los metales, el poderoso wolframio es un elemento estratégico, del que el gobierno de 🇺🇸 mantiene una reserva mínima de 6 meses... ¿Y sabes quien lo descubrió? ¡Pues dos españoles- los hermanos Elhuyar!

Este exquisito muestrario de mármoles no tendría nada de particular…¡si no fuera porque tiene unos 250 años, y es una auténtica joya del Museo de las Colecciones Reales, en Madrid! 📷A.Navarro

En el mundo, hay construcciones que parecen de ciencia ficción. Por ejemplo, las Iglesias de Lalibela, en Etiopía. Biet Ghiorgis, en concreto, fue tallada hace 700 años…¡de una sola pieza a partir del lecho de roca, y tiene 12m de altura!

Uno de los objetos arqueológicos más desconcertantes de Inglaterra es esta extraña placa de oro, encontrada sobre un esqueleto en una tumba cerca de Stonehenge. ¡Con casi 4000 años de antigüedad, asombra la perfección geométrica del dibujo con el que está decorada…! 📷BBC


Sé que conoces a muchos famosos, pero, ¿conoces a este señor? ¡Pues deberías, porque puede que nadie haya salvado más vidas a lo largo de la historia! Maurice R.Hilleman desarrolló más de 35 vacunas, incluyendo sarampión, paperas, hepatitis, varicela, meningitis y neumonía…

¡Puede parecer un vulgar recipiente de vidrio, pero cambiarás de opinión cuando sepas que tiene entre 1800 y 1900 años! Aunque te parezca increíble es romano, y lo han encontrado intacto en una excavación en Nimega (Países Bajos). 📷Bert Beelen

¿Una vieja figurilla? Y tanto...¡Tallada en marfil de mamut, y con la friolera de 25000 años a cuestas, la “Dama de Brassempouy”es una de las representaciones más antiguas y fascinantes del rostro humano! ¿Qué te parece? 📷: Museo de Saint-Germain-en-Laye

¿Sabías que en la Francia del s XIX se conocía al trióxido de arsénico como el “polvo para heredar”? ¡Hijos, cónyuges, hermanos y nietos se quitaban de en medio a sus familiares impunemente, hasta que el nuevo “Test de Marsh” acabó con el reinado de los cazadores de herencias!


No me gusta (y ya me ha pasado en algún programa de radio) que se intente establecer un debate equidistante entre una evidencia científica y una milonga como un castillo. Sencillamente, no hay nada que debatir. No es cuestión de opinión.


¡Y #TalDiaComoHoy de 1610, Galileo apunta su nuevo telescopio al firmamento y descubre 4 satélites de Júpiter, poniendo en evidencia que no todos los astros giran alrededor de la Tierra! ¡Se trata del golpe de gracia a la vieja teoría geocéntrica! 📷 NASA/JPL/DLR

¿Cuál es la representación más antigua que conocemos de los Reyes Magos? ¡Pues ésta! Se encuentra en la “capilla griega” de la catacumba de Priscilla, en Roma, y los frescos están datados entre la 2ª mitad del siglo II y la del siglo III. 📷vía elretohistorico.com


Siempre que vengo al Panteón, en Roma, tengo la misma sensación de estupor, asombro y admiración. ¡Una gigantesca cúpula de hormigón de casi 2000 años de antigüedad, intacta, con casetones dispuestos con una precisión asombrosa! ¡Te deja sin aliento!


United States Trends
- 1. Jesse Jackson N/A
- 2. hobi N/A
- 3. Happy Lunar New Year N/A
- 4. Colbert N/A
- 5. Gina N/A
- 6. Fat Tuesday N/A
- 7. Tricia McLaughlin N/A
- 8. Ramadan Mubarak N/A
- 9. Rush N/A
- 10. James Talarico N/A
- 11. Mardi Gras N/A
- 12. Rev. Jackson N/A
- 13. Tony Clark N/A
- 14. Dylan Mingo N/A
- 15. #csm229 N/A
- 16. Year of the Horse N/A
- 17. JUST ANNOUNCED N/A
- 18. #TheMandalorianAndGrogu N/A
- 19. Rest in Power N/A
- 20. Lent N/A
You might like
-
 Manuel González (Gallipato)
Manuel González (Gallipato)
@manolux4444 -
 Naukas
Naukas
@Naukas_com -
 Pere Estupinyà
Pere Estupinyà
@Perestupinya -
 JM Mulet
JM Mulet
@jmmulet -
 Alberto Aparici
Alberto Aparici
@cienciabrujula -
 Francis Villatoro
Francis Villatoro
@emulenews -
 Carlos Briones
Carlos Briones
@brionesci -
 El Pulgar del Panda (Jorge Garrido-Bautista)
El Pulgar del Panda (Jorge Garrido-Bautista)
@Pulgar_Panda -
 Lluis Montoliu
Lluis Montoliu
@LluisMontoliu -
 Carlos Lobato
Carlos Lobato
@biogeocarlos -
 microBIO
microBIO
@microBIOblog -
 Gemma del Caño
Gemma del Caño
@farmagemma -
 Círculo Escéptico
Círculo Escéptico
@cescept -
 José Ramón Alonso
José Ramón Alonso
@jralonso3 -
 Conchi Lillo🧠🔬👀
Conchi Lillo🧠🔬👀
@ConchiLillo
Something went wrong.
Something went wrong.